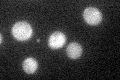

View description
Mitochondrial matrix cochaperone, acts as a nucleotide release factor for Ssc1p in protein translocation and folding; also acts as cochaperone for Ssq1p in folding of Fe-S cluster proteins; homolog of E. coli GrpE
Localization:
Intensity:
Fold change:
Significance:
-
C’ GFP library in SD

cytosol39.48 -
N' NOP1pr-GFP in SD

mitochondria172.843 -
N' TEF2pr-mCherry in SD

mitochondriaN/A -
N' NATIVEpr-GFP in SD

nucleus,mitochondria66.4875 -
N' TEF2pr-VC and Cyto-VN in SD

#N/A0 -
C’ GFP library in SD+DTT

cytosol49.161.24No -
C’ GFP library in SD+H2O2

cytosol33.240.84No -
C’ GFP library in Starvation Media
cytosol40.51.02No -
C’ GFP library on the background of Pup2-DaMP

cytosol -
C’ GFP library on the background of CCT mutant

cytosol42.06521.06534No
